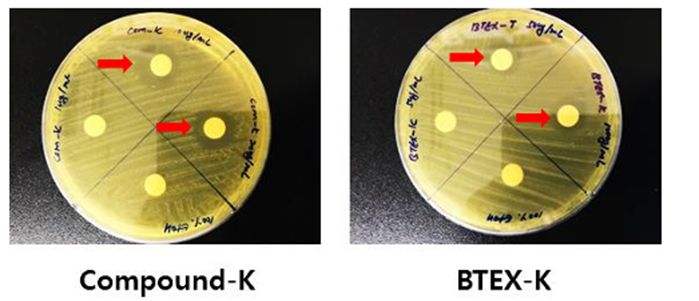

【虫歯】薬理効果評価(In-vitro)

In-vitro
Journal of Oral Biosciences 66 (2024) 19–27
1.S.Mutans菌の生育抑制
【Paper Disk 方法】
※歯牙優食菌活性抑制写真と実験統計処理結果
****p<0.0001 is compared with ethano

S. mutans(1×10⁵ CFU/ml)をBrain Heart Infusion固体培地に塗布し、BTEX-Kを濃度別に含ませた乾燥ペーパーディスクを置いて37℃で24時間培養した。
24時間後、阻止円の大きさを観察した結果、BTEX-Kは50および100 µg/mlで有意な抗菌効果を示した(p<0.0001)。ただし、50 µg/mlと100 µg/mlの間で抑制効果の差はほとんど見られなかった。
【Optical Density 方法】
※優食菌活性実験(optical density 法)統計処理結果
****p<0.0001 is compared with ethanol

S. mutans(1×10⁵ CFU/ml)を培養液に接種し、BTEX-Kを各濃度で添加して24時間培養した後、660nmで吸光度を測定した。その結果、BTEX-Kは50および100 µg/mlで有意な増殖抑制効果を示し、特に100 µg/mlで強い抑制効果が認められた(p<0.0001)。
2. 歯面細菌膜減少
歯菌細菌膜減少実験結果と実験後ガラスチューブに付着した菌写真
*p<0.05,****p<0.0001 is compared with control group


S. mutansを接種後、30℃で24時間静置培養した結果、培養液を除去するとガラス管の壁面に菌の付着(図1赤矢印)が確認された。その後、0.5 M NaOHで懸濁し、550 nmで吸光度を測定したところ、BTEX-Kは50 µg/mlから有意にバイオフィルム形成を抑制し(p<0.05)、特に100 µg/mlで顕著な抑制効果が認められた(p<0.0001)。
3. 歯面細菌膜酸性化抑制

乳酸の標準濃度グラフを作成後、対照群と試験群の含有量を比較・統計解析した結果、
100 µg/ml濃度でCompound-Kは対照群に比べ約2倍の減少を示し(p<0.0001)、
BTEX-Kは約3.2倍の減少を示した(p<0.0001)。
4. 炎症抑制
1)NO Production 阻害
※BTEX-K試料を濃度別に処理後LPSで炎症誘発48時間後NO濃度結果

RAW264.7細胞にBTEX-Kを濃度別に処理して24時間培養後、100 ngのLPSを添加し、
さらに48時間後にNO濃度を測定した結果、BTEX-Kの20 µg/ml濃度で有意な減少が確認された(**p<0.01)。
2)Cytokine測定(ELISA)
※ BTEX-K試料を濃度別に処理した後、LPSで炎症誘発48時間後cytokine生産結果

RAW264.7細胞にBTEX-Kを濃度別に処理して24時間培養後、100 ngのLPSを添加し、
さらに48時間培養したところ、BTEX-K 20 µg/mlでIL-6およびIL-1βの産生が有意に減少したことが確認された(*p<0.05、**p<0.01)。
虫歯薬理効果評価(In-vivo)
歯面細菌膜酸性化抑制

結 果
各実験群の有機酸をすべて分析した結果、紅参エキスを塗布した実験群において、lactic acidの含量が減少することを確認した。
陽性対照群対比酵素紅参BTEX-Kを塗布した実験群においては2.2倍に減少し(p>0.05)、compound-Kは約1.5倍の減少を見せた(p<0.05)。
微細硬度測定


結 果
Enamel1、Enamel2、Dentin3及びDentin4で陽性対照群と比べ、酵素紅参BTEX-K試験群で細径度がそれぞれ約1.6倍、1.2倍、1.2倍及び1.2倍で有意義に増加した。(それぞれp>0.05、p>0.01)
結 論
酵素紅参BTEX-Kの虫歯予防の効果効能試験(In-vitro)で虫歯菌生育抑制、歯面細菌膜減少、歯面細菌膜酸性化抑制、炎症抑制を確認。
酵素紅参BTEX-Kは、抗菌性、抗炎症性、再石灰化作用を有することから、虫歯の予防と治療の候補になりえる。
| BTEX-Kによる動物試験虫歯論文 ◎ BTEX-K 抗虫歯論文 ≪原文≫【PDF:5MB】 |
